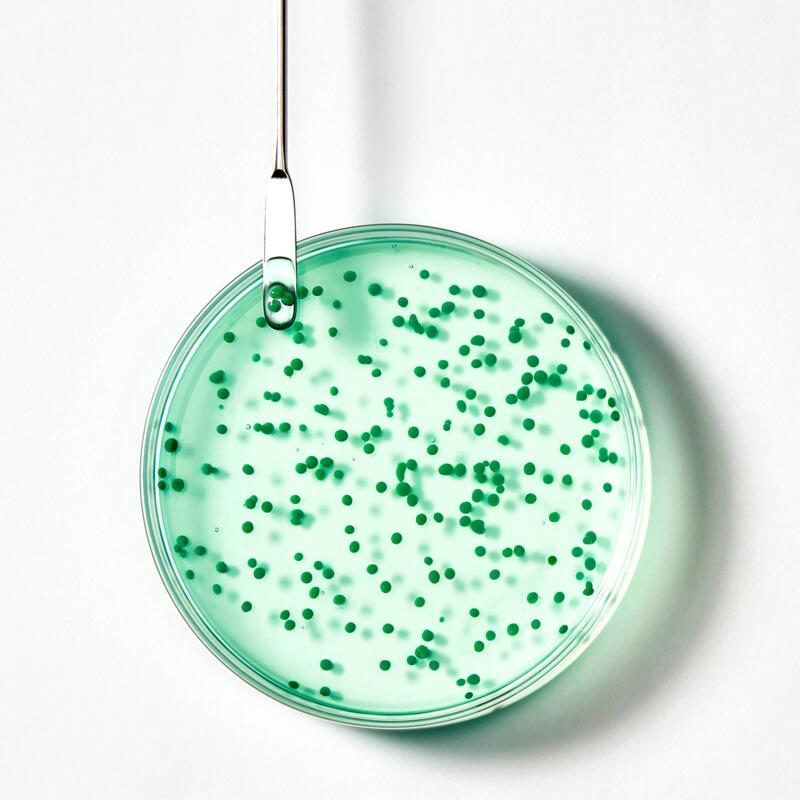

Forticea
Shampooing fortifiant revitalisant
Permanent
Forticea
Shampooing fortifiant revitalisant
Permanent Renforce la fibre capillaire
Le shampoing fortifiant revitalisant qui redonne force et vigueur à vos cheveux sans agresser le cuir chevelu.
-
Formule aux Biosphères d’Huiles essentielles pour fortifier et revitaliser le cuir chevelu .
-
97% d'ingrédients d'origine naturelle. Sans silicone. Sans tensio-actifs sulfatés.
Utilisable par Adolescents - Adultes
Type de cheveux Tous types de cheveux - Soins sans sulfate - Soins sans silicone - Tous types de cuir chevelu
Besoin Nettoyant - Energisant - Fortifiant
Fabriqué en France
Ce shampoing fortifiant usage fréquent apporte les éléments nutritionnels et énergétiques indispensables pour renforcer tous les types de cheveux. Enrichi en Guarana, puissant énergisant naturel, en Vitamines B3, B5 et en Huiles essentielles, il revitalise et purifie le cuir chevelu tout en réduisant l’excès de sébum. Les Huiles essentielles d'Orange, de Lavande et de Romarin sont encapsulées dans des Biosphères qui éclatent délicatement sous les doigts à l'émulsion, pour libérer leurs précieux pouvoirs dans une mousse onctueuse au parfum frais et vivifiant. La chevelure est plus vigoureuse, légère, facile à coiffer au quotidien. La fibre est renforcée et les cheveux éclatants de santé.
Avantages
Une texture iconique aux Biosphères d’Huiles essentielles. Telle une invitation au massage, elles éclatent délicatement sous les doigts lors de l’application, pour libérer leurs précieux pouvoirs directement sur le cuir chevelu, dans une mousse onctueuse et très sensorielle.
Bénéfices
• NETTOIE EN DOUCEUR : formulé à 97% d'ingrédients d'origine naturelle et sans tensio-actifs sulfatés, ce shampoing purifie le cuir chevelu et renforce les cheveux dès la racine, tout en douceur.
• FORTIFIE et REVITALISE : enrichi en extrait de Guarana, énergisant naturel, en Vitamines et en Huiles essentielles, il aide les cheveux à retrouver force et vitalité. Plus vigoureux, ils sont légers et faciles à coiffer.
• FORMULE SENSORIELLE : la texture gel transparente et pétillante, gorgée de précieuses Biosphères d'Huiles essentielles, enveloppe les cheveux d'un parfum frais et vivifiant, aux notes fusantes d'Agrumes et de Thym.
*Selon test OCDE310B
Le Green Impact Index est un outil d’affichage de l’impact environnemental et sociétal des produits cosmétiques, des compléments alimentaires ainsi que des produits de bien-être et santé familiale, basé sur la méthodologie décrite dans l’AFNOR Spec 2215. Développé en collaboration par 21 entreprises, associations et fédérations, il évalue vos produits sur plus de 50 critères pour toujours plus de transparence !

Impact environnemental
Formule
Formule biodégradable*
Formulé pour limiter l’impact sur le milieu aquatique***
Formule d’origine naturelle 97 %
*Selon un test OCDE 301 ou méthode indice de biodégradabilité
*** Selon un test OCDE 301 et classement CLP de la formule
Packaging
Emballage comportant au moins 31 % de matières recyclées
Emballage entièrement recyclable
Emballage allégé
Fabrication
Fabriqué et conditionné dans une usine certifiée pour l’environnement****
Formule fabriquée à froid sans aucune chauffe
****Selon la norme ISO 14001 et/ou 50001
Transport
Impact CO2 moyen du transport des matières premières (≥ 70 et < 140 g CO2 eq. )
Impact sociétal
Impact sociétal
Produit fabriqué et conditionné dans une usine aux normes sociales exigeantes
Furterer est une marque du Groupe Pierre Fabre, labellisé au plus haut niveau Exemplaire du label Engagé RSE et Responsibility Europe d’AFNOR Certification, consolidant ainsi un engagement de longue date dans la contribution au développement durable.
Ne contient pas d’ingrédient d’origine animale

 "
"Shampooing fortifiant revitalisant

Laisser un avis